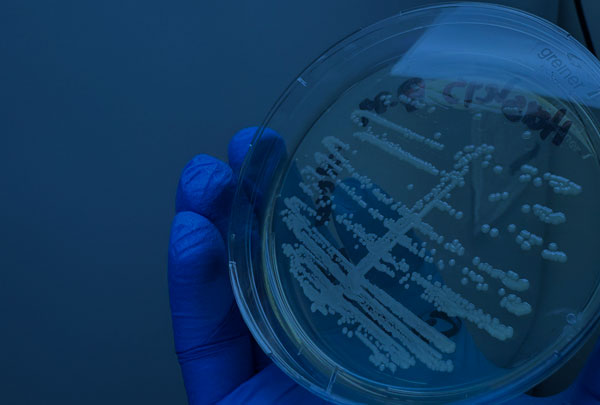

During the Costa Rica 2025 Brucellosis International Research Conference we will cover the following thematic areas
Each session, chaired by an expert, will host keynote lectures followed by oral presentations.
Poster sessions will offer further opportunities to present and discuss data.

Immunology & Pathogenesis
- Acquired and innate immunity
- Intracellular life
- Host-pathogen interaction
- Virulence factors
- Intracellular life
- Host-pathogen interaction
- Virulence factors
Molecular & Cellular Microbiology
- Metabolism
- Metabolome
- Gene regulation and expression
- Cell structure
- Metabolome
- Gene regulation and expression
- Cell structure

Evolution & Taxonomy
- New species or strains
- Phylogeny
- Genome evolution
- Genome Structure
- Phylogeny
- Genome evolution
- Genome Structure

Wildlife & New hosts
- Emerging brucellosis
- New hosts
- Wildlife clinical reports
- New hosts
- Wildlife clinical reports

Vaccines
- Classical vaccination
- New vaccine candidates
- New vaccine candidates

Epidemiology
- Surveillance, control and, eradication
- Geographic distribution
- National and regional programs
- Human brucellosis and brucellosis domestic animals (clinical reports)
- Geographic distribution
- National and regional programs
- Human brucellosis and brucellosis domestic animals (clinical reports)

Diagnosis & Treatment
- Classical and new diagnostic tools
- New and classical treatments
- Potential therapeutic targets
- New and classical treatments
- Potential therapeutic targets